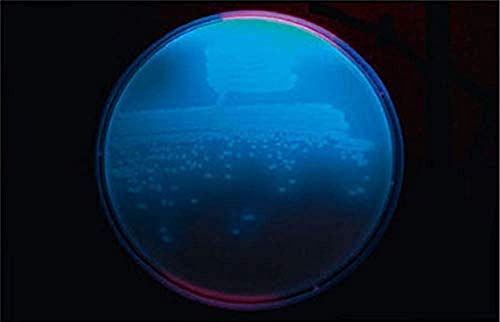

Biolab DH 155256 Ceppo di Bacteria: Pseudomonas Fluorescente, Scatola di Pietra
Confezione da 1PZ
Molto efficace.
Semplicità d'uso
(
Vai al Negozio
per ulteriori informazioni )
Il prodotto o servizio visualizzato potrebbe non essere aggiornato e non più disponibile.
Il prezzo visualizzato può essere aumentato dall’ultima volta che il sistema l'ha aggiornato.
Il prezzo attuale del prodotto sul sito del venditore, al momento dell’acquisto, determinerà il prezzo di vendita.
Non è tecnicamente possibile aggiornare in tempo reale i prezzi e la disponibilità sopra visualizzati.
In qualità di affiliato Amazon ultimiPrezzi riceve un guadagno dagli acquisti idonei.
I prezzi visualizzati in ultimiPrezzi sono uguali o inferiori di quelli proposti direttamente nel sito del venditore.
Non sarà richiesto all'utente alcun importo aggiuntivo.
Non sono ammessi accordi con maggiorazioni di prezzo che comportino un costo aggiuntivo per l’utente.
Questa pagina fornisce contenuti originali coperti da copyright: recensioni, commenti, valutazioni e grafico prezzi, funzionalità di tracciamento prezzi e notifiche multi piattaforma, gestione dei preferiti.
ultimiPrezzi non si può ritenere responsabile della mancata prestazione del Servizio o mancato funzionamento dei mezzi elettronici di comunicazione, di imprecisioni e relativi errori o incompletezza delle informazioni fornite.
© Copyright 2010-2026 Fabrizio Fichera. Tutti i diritti riservati. P.I. 02554810180